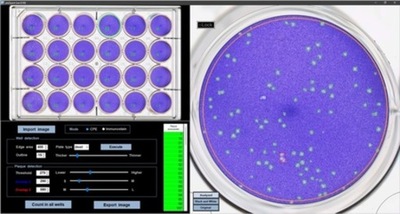
病原ウイルスの感染力を効率的に数値化できるソフトウェア「plaQuest」を開発

Tokyo
-

「エコプロ2025」に出展 ~クイズとワークショップで自動車リサイクルの取り組みを学ぼう!~
-

210店舗目のサブウェイが長野県に出店! 『アイシティ21店』 12月5日(金)オープン
-

【東北限定】冬の運だめしキャンペーンを開催
-

病原ウイルスの感染力を効率的に数値化できるソフトウェア「plaQuest」を開発
-

「パンダの穴」の人気キャラクター「幽麺(YUMEN)」 初の絵本『ゆうめん』12月26日発売決定!
-

平成ガールの思い出がよみがえる!生誕40周年の『BETTY’S BLUE』文具雑貨シリーズが11月下旬より発売
-

パーキンソン病における体重減少の謎を解明:体脂肪の減少と、エネルギー代謝のシフトが関与
-

累計販売台数 10万台を突破! A型看板の定番「グリップA®」シリーズ
-

ロジカ式の「人の感情に寄り添う共感AI」が台湾でも特許成立
-

豪シドニー近郊で木造9階建ての賃貸用集合住宅を開発 ~マスティンバー建築で環境負荷を低減~
-

とろける口どけの本まぐろが楽しめる『本まぐろと昆布そば』を12月9日(火)から関東店舗で先行販売!
~今年は2種類のまぐろが楽しめる「まぐろのお楽しみ膳」が新登場~ -

デニーズ、冬の人気メニュー『ロッシーニ風』が12月17日(水)より登場
今年はハンバーグ仕立ても登場し、12月3日(水)より先行販売 -

フリーランス、物価高で経費が増加する一方で収入も増加
-

塩分過剰摂取の解決に向けて
「塩分オフセット技術」を有するトイメディカル社と協業 -

紀文食品、「2026年 紀文・お正月百科」を発表。お正月に関する全国調査を実施。
-

【横浜市立大学】UHRF1によるヌクレオソーム認識とヒストンH3ユビキチン化の構造基盤を解明
-

70~74歳の医療「2割負担」で医療費は減少、健康悪化は確認されず
-

脂肪由来幹細胞の分泌因子による心筋保護の新戦略